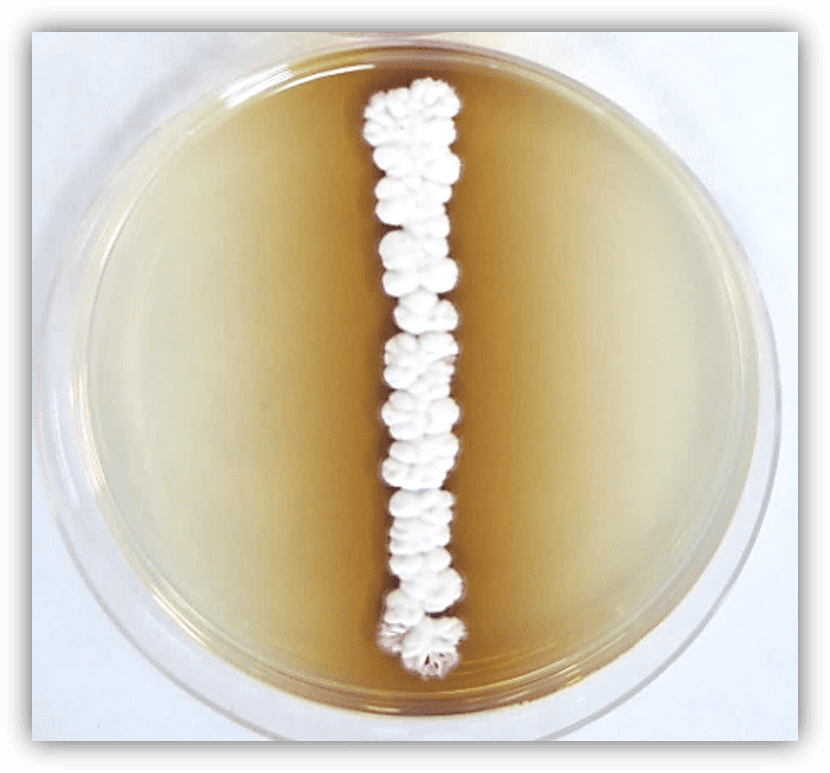
轮枝链霉菌属网
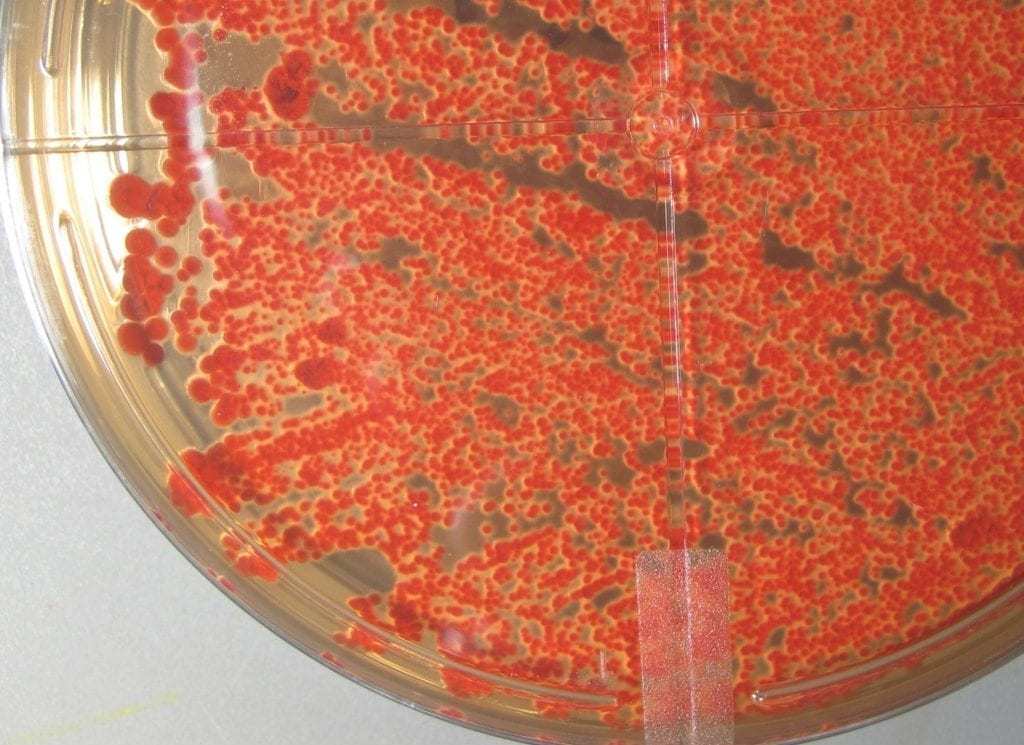
导致乙烯基和泡棉上出现粉红色污渍的细菌
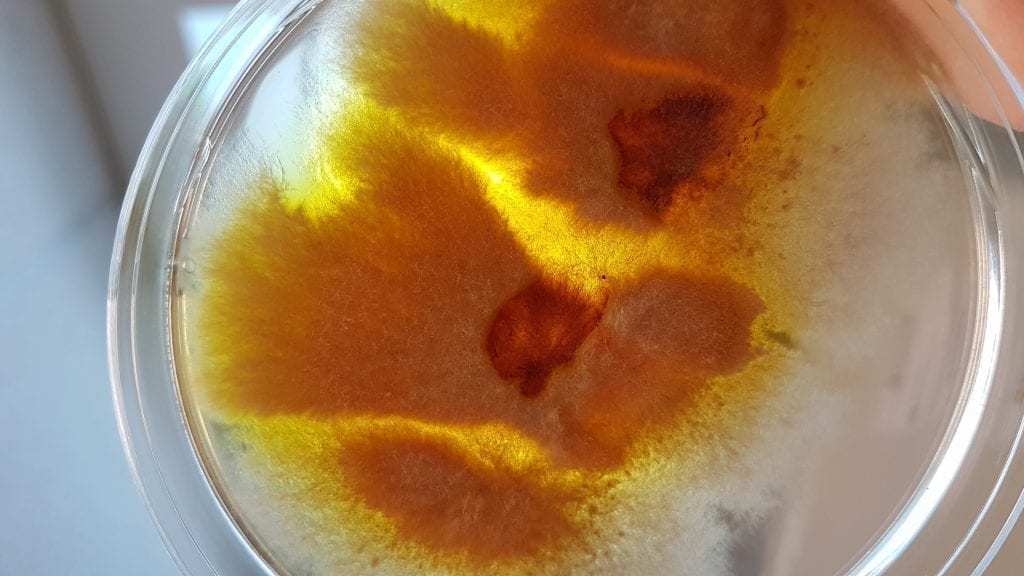
从乙烯基中分离出的霉菌

2020 年 2 月 25 日更新,包含油毡地板上的粉红色污渍的相关信息(详情参阅下文)。
随着划船季的临近,一个常见问题亟需解决:乙烯基船只座椅上出现粉红色污渍。如果您拥有自己的船只,想必不会对此问题感到陌生。
[caption id="attachment_2567" align="aligncenter" width="594"]

乙烯基船只座椅上的粉红色污渍(图片来源:thehulltruth.com)
乙烯基上的这些粉红色污渍是什么?
船只座椅上的这些粉红色污渍通常看起来像打翻的果汁,在白色的乙烯基材料表面非常显眼。
大多数人很自然地认为这是由船只座椅上的粉红色霉菌所引起。
实际上,这些污渍是由一种源自细菌的染料引起。这种染料由放线菌目链霉菌属中的一种细菌产生。这种生物体以前被称为"轮枝链霉菌属网粉红染色细菌"。
它不是导致粉红染色问题的唯一物种,但却是最常见的元凶之一。
这些细菌可以在乙烯基表面以及含乙烯基成分的泡棉中发现。像大多数细菌一样,它们喜爱潮湿温暖的环境。
从本质上讲,船只是它们的温床,拥有其生长所需要的一切条件。
油毡、乙烯基地板、水池衬里、PVC 乙烯基屋顶膜以及任何其他浅色塑料和聚合物材料与水接触的区域都易受到轮枝链霉菌属网粉红色污渍的影响。
请参阅下文,查找有关乙烯基和油毡地板上的粉红色污渍的更多信息。
乙烯基船只座椅上的粉红色污渍是如何产生的?
这种染料也被称为灵菌红素 (prodiginine) 色素,可以从源头迁移很远的距离。因为这是一种水溶性染料。
即使污渍本来只是一个小点,如果沾了湿气,这种染料可以继续从源头向外移动。这为污渍的扩大创造了条件。
此外,如果这些细菌生长在某种材料(例如船只座椅内的泡沫缓冲垫)中,染料很容易向上迁移。
这将永久污染座椅顶部的乙烯基家具装饰。
[caption id="attachment_2029" align="aligncenter" width="500"]
粉红色染料如何从粉红染色细菌迁移的示例,轮枝链霉菌属网(图片来源:Thomson Research Associates, Inc.,Ultra-Fresh 公司)。
在培养皿环境中,当观察生物体表面时,细菌通常呈白色或浅粉色(请参见上图)。
然而,当观察培养皿的底面时,可以观察到浓郁的粉红色彩(请参见下图)。
[caption id="attachment_1861" align="aligncenter" width="500"]
这种细菌通常是塑料、乙烯基和泡棉染上粉红色的原因。它通常被误认为粉红色霉菌(图片来源:Thomson Research Associates, Inc.,Ultra-Fresh 公司)。
在"现实世界"中,染料的颜色可以从红色到紫色或粉红色到棕色不等,具体取决于生长环境(食物来源、温度、湿度等)。
油毡地板为什么会出现粉红色污渍?
您浏览我们的博客可能是因为担心您的油毡或乙烯基地板上出现了粉红色污渍。为什么乙烯基地板会变成粉红色?
与上述相同的细菌最有可能是变色的原因,特别是如果地板下有湿气的话。
细菌会在地板下生长,并且这种染料会随着时间的推移向上迁移,导致油毡地板上会神奇地显现神秘的粉红色污渍。
[caption id="attachment_2032" align="aligncenter" width="500"]

油毡地板被产生染料的细菌染成粉红色(图片来源:truckmountforums.com)
粉红色污渍并不是乙烯基上可能形成的唯一类型。
如下图所示,可能会出现橙色到铁锈色斑点,这来源于其他可以生成色素并形成污渍的霉菌。
[caption id="attachment_2035" align="aligncenter" width="500"]

在油毡地板上发现的锈斑是由一种会产生橙色或铁锈色/金属色色素的霉菌引起的(图片来源:truckmountforums.com)
以下照片在我们的实验室拍摄,展示一种从乙烯基中分离出来的颜色鲜艳的真菌。
这种真菌可能是导致油毡或乙烯基地板上出现铁锈色斑点的原因。注意从生物体向外扩散的铁锈色/橙色/黄色色素。
[caption id="attachment_2890" align="aligncenter" width="1024"]
从被染色的乙烯基中分离出的霉菌(图片来源:Thomson Research Associates, Inc.,Ultra-Fresh 公司)
如何去除乙烯基材料上的粉红色污渍
确保船体保持干燥是减缓细菌(或霉菌)生长速度的一种方式。请务必正确清洁和存放船只,同时将湿度保持在最低水平。
从乙烯基中去除粉红色污渍并不容易。
如果已有粉红色污渍形成,有一些清洁剂可以减轻染色状况,如 Gestalt Scientific 公司出品的 Pink Away,相关文章最近发表在《划船》的电子杂志上。
但是,还没有任何产品可以完全清除这种粉红色污渍。
如果要尝试使用漂白剂来清洁这些污渍,请务必小心使用。它会对乙烯基部分和接缝处造成不必要的损坏。
在粉红色污渍问题出现之前,请确保做到最好的养护工作。请咨询您的家具装饰提供商,了解他们使用的产品中是否包含 Ultra-Fresh 产品。
Ultra-Fresh 产品如何帮助清洁乙烯基和泡棉上的粉红色污渍
Ultra-Fresh 是一种抗菌剂,有助于防止轮枝链霉菌属网粉红染色细菌的生长。它还可以抑制多种其他类型可导致异味和污渍的微生物。
在产品制造流程中加入抗菌添加剂,这种添加剂适用于船只座椅中的所有组件(包括乙烯基,泡棉和接缝线处)。
它还具有能控制难闻气味并延长聚氨酯泡沫和乙烯基老化(导致乙烯基上产生粉红色污渍的生物体有一股典型的泥土气味)的额外优点。
Ultra-Fresh 技术非常高效。截至 2020 年 2 月 25 日,其产品已在 EPA 注册并被列入 BPR 合格供应商清单,其产品不含加州 65 号提案中警告清单上的任何化学物质。
用于评估乙烯基上粉红色污渍的检测方法
ASTM E1428 是用于评估材料对于粉红色污渍抗染色程度的一种常见检测方法,该方法使用的检测生物体为轮枝链霉菌属网粉红染色细菌。
将粉红染色细菌涂抹在含有营养物质的琼脂板表面,以支持其生长。
将测试样本放置在拭子表面上方并培养 14 天。之后,将样本从表面剥落,并评估粉红色染色的程度。
以下是经过抗菌添加剂处理的乙烯基以及未经处理的乙烯基样本对比示例:
[caption id="attachment_1094" align="alignright" width="350"]

经过 Ultra-Fresh 抗菌处理的乙烯基能抑制细菌生长,防止粉红色污渍的出现。
[caption id="attachment_1095" align="alignleft" width="350"]

未经处理的乙烯基被轮枝链霉菌属网染成了粉红色,产生染料作为废物副产品。
总结
遗憾的是,从乙烯基中完全去除粉红色污渍在事后很难完成。如果您的产品在保修期内,请与制造商联系,看看是否可以采取任何措施来更换该产品。
- 确保产品采用已证明通过 ASTM E1428 检测方法的抗菌技术进行处理。
- 保持产品清洁,防止污垢产生。
- 限制湿气:对于船只,应确保其内部装潢尽量保持完全干燥。不要将湿毛巾或泳衣留在座位上。对于油毡或乙烯基地板,请注意地板下方可能出现的任何湿气问题。
更多有趣文章:
我们的抗菌专长
汤研联 (TRA) 是抗菌处理领域的全球领导者,60 多年来一直为成品提供抗细菌和真菌功效的技术。
